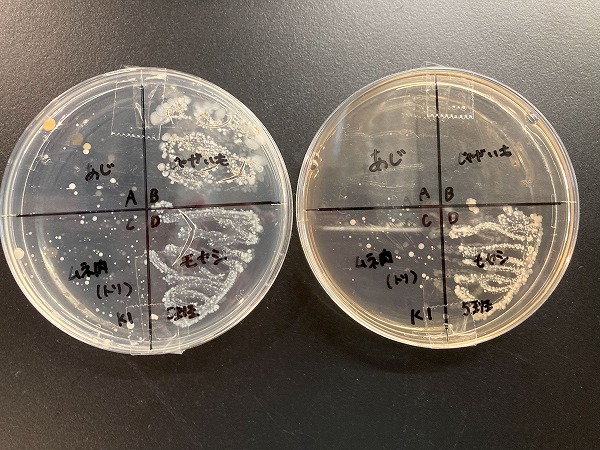

暑さに負けるな!食中毒を防ぐ夏の実験室 ~「食品の安全と衛生」の授業の様子~
蒸し暑い日が続いていますね。
辻調グループ東京校の学生たちは、夏休み前のラストスパートに取り組んでいます。
近年の夏は、日中の気温が35℃を超える猛暑が当たり前になりつつあります。
人間にとっては過酷な環境でも、細菌にとってはむしろ快適な気候。
たとえば、食事の残りを冷蔵庫に入れ忘れてしまい、夕方にはすっかり傷んでいた...そんな経験はありませんか?
この時期は特に、食中毒への注意が必要です。
お弁当を持参する際には、保存性の高い食材を選び、
保冷剤や保冷バッグを活用するなど、しっかりとした対策が求められます。
今回は、「食品の安全と衛生」の授業で行われた微生物検証実験の様子をご紹介します。
食品の安全と衛生の授業 ~食材由来の微生物の検証実験~
「食品の安全と衛生」の授業では、安全でおいしい食を提供できる
料理人・菓子職人になるために必要な知識と技術を学んでいます。
前期(4月〜9月)の授業では、特に食中毒を防ぐための衛生管理について重点的に学習しています。
今回の授業では、食品と食中毒の関係を学び、食材の取り扱いについて理解を深めました。
先生の説明を受けた後、いよいよ実験スタートです。
班ごとに、肉・魚・野菜・果物などからテーマを決め、食材に付着している菌を調べる実験を行いました。
調査には「寒天培地」と呼ばれるゼリー状の培養素材を使用します。
これは菌が育ちやすい栄養分を含んだ透明なゼリーのようなもので、
菌を付けて増殖させることで、肉眼で菌の存在を確認できます。
キュウリの菌を採取している様子
鯵の口の中の菌を採取している様子
まず、滅菌された綿棒で食材の表面をこすり、菌を採取します。
次に、あらかじめ寒天培地を流し固めたシャーレに、綿棒で採取した菌を塗布します。
今回は、一般細菌と大腸菌群の両方を観察できるよう、2種類の培地を使って実験を行いました。
採取した菌を培地に塗っている様子
その後、シャーレのふたを閉じ、36℃の保温庫で48時間保存して菌を培養します。
普段は肉眼では見えない菌が増殖し、丸い塊(コロニー)として目に見えるようになります。
菌の種類によって増殖のスピードが異なるため、コロニーの大きさにも違いが見られます。
培養後の寒天培地。菌のコロニーが銀河のように見えます
培養後は、シャーレを観察し、結果を考察して班ごとに発表を行いました。
実験結果をもとに、食品の取り扱いについて発表している様子
学生の気づき(発表より抜粋)
• 食材を洗浄することの大切さを痛感した実験だった。
• 魚を生で食べる場合は、保存方法を適切に守ることや、加熱調理の際に火の通し方に注意することが、
食中毒を防ぐうえで重要だと分かった。
• 加熱が必要な食品にはしっかり火を通すことはもちろん、
加熱しない食品についても、洗浄や消毒の重要性を改めて感じた。
学生たちは、原材料となる食品に菌が存在することを実際に確認し、
衛生的な食品の取り扱いについて深く学ぶことができました。
次のステップへ
夏休み明けには、9月に学んだ内容をもとに定期試験が行われます。
そして10月から始まる後期の授業では、飲食店で安全かつおいしく料理を提供するための、
より実践的な衛生管理について学んでいきます。
後期の終わりには、辻調東京祭(学園祭)も予定されており、すでにその準備もスタートしました!
第1回 辻調東京祭運営委員会の様子。各クラスの代表が集まって顔合わせをしました。
私たち教員も、学生と一緒に楽しみながら学んでいます。
食を通じて、ワクワクするような体験を一緒にしてみませんか?
今後も教職員一同、全力で取り組んでまいります。どうぞお楽しみに!
~プロフィール~
辻調理師専門学校 東京
専門講義科目グループ
食品の安全と衛生、くいしんぼうラボ 担当
井原啓子
管理栄養士、中学・高等学校教諭免許(家庭)取得
専門は、品質管理、食品科学、家庭科
「辻調理師専門学校」「辻製菓専門学校学校」「エコール 辻 東京」を経て、「辻調理師専門学校 東京」勤務。
趣味:水泳(ほぼ毎日、泳いでいます)。食べることや作ること、食材巡りも大好きです。
大学で野生キノコの研究をしたことがきっかけで、キノコが大好きになりました。
今年も、キクラゲの栽培にもはまっています。もう間もなく収穫できそうです。


